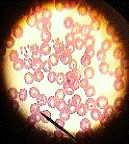

Пироплазмоз - трансмиссивная болезнь собак
Содержание
1. Определение заболевания
. Возбудитель
. Эпизоотические данные
. Патогенез
. Симптомы
. Диагностика
. Патологоанатомические изменения
. Лечение
. Профилактика. Рекомендация
владельцу
Литература
1. Определение заболевания
Пироплазмоз - трансмиссивная (возбудители
болезни передаются от одних животных другим при помощи клещей) болезнь собак,
возбудители данной болезни являются простейшие, которые чаще всего находятся в
эритроцитах а так же в других клетках ретикулоэндотелиальной системы. Возбудитель
локализуется в эритроцитах, иногда в плазме крови, нейтрофилах, моноцитах и др.
Данное заболевание среди семейства псовых может протекать остро и иногда
хронически. Кроме собак болеют енотовидные собаки, лисицы и другие пушные
звери.
. Возбудитель
Биология возбудителя. Возбудитель пироплазмоза у
собак и других животных - паразит Piroplasma canis (Babesia
canis)-одноклеточный паразит овальной, амебовидной, круглой или грушевидной
формы. Имеет весьма большие размеры, чем пироплазмы других животных.
Практически полностью заполняет весь эритроцит. В начале заболевания чаще
встречаются одиночные паразиты. после увеличивается число парногрушевидных
форм.
Жизненный цикл пироплазм протекает в двух
хозяевах - животные и у клещей переносчиков. Размножение в организме животного
происходит в крови путем простого деления на два или путем почкования, а в
организме клещей пироплазмы размножаются в тканях и гемолимфе, а также в яйцах
возможно шизогональным путем. В самках клещей развитие паразита происходит в яичнике,
далее продолжается в яйцах, вышедших из них личинках, затем в нимфах и имаго. В
последних пироплазмы инвазируют слюнные железы и при сосании клещом крови
животных они проникают в кровь и таким путем возникает инвазия пироплазмами
восприимчивых животных. У одной самки рождается сотни и тысячи зараженных
пироплазмами клещей.
На данном рисунке представлен цикл развития
пироплазм после попадания в красные кровяные тельца.

Заражение
. Эпизоотические данные
Пироплазмоз у собак чаще встречается в средней
зоне Европейской части России, на Урале, в Западной Сибири, на Украине, в
Крыму, на Кавказе и в других странах. Так же постоянно регистрируется в городах
России. Эпизоотологические характеристики данного заболевания за последние
время поменялись. Раньше считалось, что этой болезнью животное может быть
подвержено лишь на природе, т.е. в лесу. В простонародии болезнь назвалась
«Лесная болезнь», сейчас же эпизоотологическая картина в корне поменялась, с
обращениями в ветеринарные клиники поступают городские животные. Собаки чаще
всего заболевают пироплазмозом после нападения клещей в городских парках и
скверах, и даже во дворах. В настоящее время регистрируется значительное
количество случаев заболевания беспородных и помесных собак.
Переносчиками возбудителя пироплазмоза собак
являются взрослые иксодовые клещи рода Dermacentor.
. Патогенез
canis и их токсины являются первыми
патогенетическими факторами, оказывающими аллергическое воздействие на организм
и вызывающими нарушение функций органов кроветворения и лизис эритроцитов у
собак. В процессе патогенеза заболевания решающее значение имеет разрушение
эритроцитов, внутри которых происходит развитие паразитов. У 80% больных
животных разрушение эритроцитов приводит к значительному уменьшению
периферической крови, что и определяет низкий уровень гемоглобина. Количество
эритроцитов в некоторых случаях уменьшается до 2.5 - 3.0*10№І/л, а количество
гемоглобина - до 35 - 40 г/л, что приводит к развитию анемии гемолитического
типа.
Освобождающийся гемоглобин остается растворенным
в плазме крови и частично всасывается эритроцитами, которые становятся
гиперхромными, а иногда выделяется с мочой (гемоглобинурия - 57%), что является
одним из характерных признаков болезни. Какая-то часть гемоглобина превращается
клетками РЭС в билирубин и гемосидерин. Так, в 54.5% случаев у собак, больных
пироплазмозом, отмечается повышение уровня билирубина (до 330 - 362 мкмоль/л),
что приводит к возникновению гемолитической желтухи, принимающей впоследствии
гемолитически - гепатогенный характер.
Недостаток эритроцитов и гемоглобина вызывает
нарушение функций всех органов и приводит к тяжелым процессам. При этом
накапливается много недоокисленных веществ, что отражается, в первую очередь,
на сердечно - сосудистой системе. Происходит ослабление функций миокарда, а в дальнейшем
расстройство кровообращения. В результате развивается учащение сердцебиения,
застой в большом и малом кругах кровообращения, отек легких, нарушается
газообмен, наблюдается гипоксемия, ацидоз.
Токсины воздействуют и на нервную систему, что
проявляется угнетением и повышением температуры. Если происходят необратимые
изменения в ЦНС, то прогноз болезни неблагоприятный.
Одновременно в организме происходят нарушения в
желудочно-кишечном тракте, что проявляется усилением перистальтики, снижением
аппетита (у 89% больных собак), рвотой (у 44%), ухудшением процессов
переваривания и всасывания пищи. Постепенно развивается катаральное воспаление,
ослабление перистальтики, метеоризм. В начале заболевания наблюдается понос
(12%), а затем запор. Животные заметно худеют.
Нарушения кровообращения и интоксикация
организма приводят к нарушению функций почек (альбуминурия, олигурия, анурия).
Как результат, уменьшение выделения токсических веществ из организма. Изменения
в сосудах способствуют резкому увеличению их проницаемости, приводящей к
отечности перикапиллярной ткани диапедезным геморрагиям, аноксемии, снижению
способности обезвреживать токсические продукты. Позднее развиваются более
тяжелые изменения, указывающие на тяжелую интоксикацию всего организма. При этом
кровь приобретает водянистый вид, морфология эритроцитов изменяется,
развивается анизоцитоз, пойкилоцитоз, полихроматия, появляются эритроциты с
базофильной зернистостью.
В острых случаях отмечают небольшой лейкоцитоз.
При этом в первые дни наблюдается кратковременное преобладание эозинофилов, и в
лейкоцитарной формуле отмечается сдвиг влево - до юных, которые затем уступают
место нейтрофилам, а в дальнейшем регистрируют лимфоцитоз (в 50%).
Лейкоцитопения выявляется у животных с хроническим течением заболевания, за
счет снижения уровня нейтрофилов.
Изменение биохимических процессов приводит к
гиперплазии клеток РЭС, т. е. к увеличению объема печени, селезенки и
лимфоузлов. Одновременно с этим повышается уровень общего белка за счет
глобулиновых фракций, при одновременном снижении концентрации альбуминов.
Процесс выздоровления при пироплазмозе собак
длительный и при тяжелой форме нередко осложняется миокардитами, нефритами и
гепатитами. Таким образом, в зависимости от вирулентности возбудителя, от
степени восприимчивости и резистентности животного инвазия может протекать как
тяжелый процесс с нарастающими явлениями сердечно - сосудистой недостаточности.
В результате развивается отек легких и возможна смерть.
. Симптомы
Первый подъем температуры у собак наблюдается
после отпадения первой напившейся самки клеща.
Различают острое (у лисиц еще и сверхострое) и
хроническое течение болезни.
Острое течение пироплазмза у собак
характеризуется повышением температуры тела до 41-42°С, удерживающимся в
течение 2-3 суток. Собаки становятся апатичными, вялыми, отказываются от корма,
дыхание тяжелое, учащенное.
Слизистые оболочки ротовой полости и глаз
вначале гиперемированы, а затем становятся анемичными с желтушным оттенком. В
тяжелых случаях зубы также становятся желтушными. Пульс слабый, нитевидный (до
36-48 ударов в минуту). На 2-5-е сутки появляется гемоглобинурия -
"кровомочка". Походка становится затрудненной, особенно ослабевают
задние конечности, с последующим парезом и параличом. Развивается атония кишечника.
Указанные признаки регистрируются в течение 3-7 суток. Затем температура
снижается до субнормальной (36-35°С), и болезнь, как правило, заканчивается
летально.
Хроническое течение пироплазмоза у собак
наблюдается у собак с повышенной резистентностью организма, а также у
беспородных и ранее переболевших пироплазмозом. Температура тела повышается до
40-41°Столько в первые дни болезни, затем нормализуется. Животные быстро
утомляются, аппетит ухудшается. Периоды улучшения состояния сменяются
депрессией. Запоры чередуются с поносами. Характерные признаки -
прогрессирующая анемия и кахексия. Продолжительность болезни 3-6 недель.
Выздоровление наступает медленно - от 3 недель до 3 месяцев. В зависимости от
течения заболевания продолжительность его варьирует от 3-7 дней (острое
течение) до 3 месяцев (хроническое).
Пироплазмоз у собак начинается с повышения
температуры тела до 40-42˚С с последующим снижением до нормальной и
субнормальной (35-36˚С), отмечается снижение аппетита или полный отказ от
корма, быстрая утомляемость, вялость, животные становятся апатичными. В
результате разрушения эритроцитов крови гемоглобин частично выделяется с мочой,
отчего последняя приобретает красный цвет (гемоглобинурия), а частично
перерабатывается в желчные пигменты (билирубин), что приводит к желтушной
окраске слизистых и серозных оболочек, кожи, подкожной клетчатки и даже мышц.
Усиливаются компенсаторные функции сердечнососудистой и дыхательной систем,
которые постепенно ослабевают. Снижается газообмен, нарушается
кислотно-щелочное равновесие. Наступает кислородное голодание и, как следствие,
одышка, застойные явления, возможен отек легких. В результате увеличения
порозности сосудов появляются отеки и кровоизлияния в различных органах и
тканях. Снижается количество лейкоцитов, эритроцитов, гемоглобина. Отмечается
анизоцитоз, пойкилоцитоз, полихроматофилия, базофильная зернистость в
эритроцитах. Сами паразиты и продукты их жизнедеятельности вызывают серьезные
нарушения функций различных органов и систем, последствия которых могут
оставаться на всю жизнь: поражения печени и поджелудочной железы, дистрофия
почек, миокардит и т.д. Кроме того, развивающиеся при этом вторичные
иммунодефицитные состояния, обусловливают повышенную восприимчивость организма
к бактериальным и вирусным инфекциям.
Одним из симптомов пироплазмоза у собак является
гематурия - появление крови в моче. Другой признак - повышение температуры.
Нужно отметить, что оба эти симптома являются кратковременными: около суток
наблюдается повышение температуры, и столько же - проявление гематурии. Затем
внешне все приходит в норму. Но начинает развиваться анемия, которая
обусловлена потерей эритроцитов - переносчиков кислорода ко всем органам. При
дальнейшем развитии болезни наблюдаются увеличение печени и селезенки,
вызванные массированной интоксикацией. Но одним из наиболее неприятных
проявлений пироплазмоза является гипоксия мозга, в результате чего развиваются
тяжелые, а иногда - необратимые поражения центральной нервной системы.
Довольно часто пироплазмоз у собак сопровождается
лептоспирозом и гепатитом, реже - другими инфекционными заболеваниями. Иммунная
система организма, ослабленная в результате борьбы с пироплазмой, не может
обеспечить надежную защиту от других инфекций. Следует оговориться, что это
практически не относится к собакам, которые были вакцинированы от упомянутых
болезней. Ситуация усугубляется еще и тем, что сезонные пики заболеваемости
пироплазмозом, лептоспирозом и гепатитом практически совпадают. Поэтому если
собака не была привита и заболела пироплазмозом, то она имеет высокий шанс
получить дополнительно еще какую-нибудь инфекционную болезнь. Поэтому при
проведении лабораторных анализов параллельно с тестами на наличие пироплазмы мы
всегда проводим серологические исследования, чтобы выявить другие инфекции, и,
к сожалению, нередко их находим. А ведь и пироплазмоз, и лептоспироз являются
тяжелейшими заболеваниями, и даже одного из них вполне достаточно, чтобы
потерять собаку.
. Диагностика
Болезнь диагностируют только после исследования
мазков крови, окрашенных по Романовскому. Диагностика пироплазмоза собак
состоит из 5 последовательных действий:
. Оценка клинических признаков и предположение о
развитии пироплазмоза. Сообщения владельцев собак о покусе клещом или походы в
опасные места (хотя сейчас распространение клещей повсеместное), а также
наличие темной мочи.
Наиболее частые клинические признаки
пироплазмоза собак:
высокая температура 40 и более градусов
общая вялость, слабость и отказ от еды
темная моча
иногда понос и рвота, возможно ярко желтого или
оранжевого цвета
. Далее проводится оценка и анализ мочи. Моча
может быть внешне от немного более концентрированной, до бурого или даже
черного цвета. При анализе обнаруживается гемоглобин, может быть билирубин. В
самом начале пироплазмоза моча может быть нормального цвета и не содержит
гемоглобина - как правило, повторный анализ через 12-24 часа уже показывает
появление гемоглобина, а цвет при своевременном лечении пироплазмоза может не
изменится.
. Если нет окончательного убеждения, что это
пироплазмоз, можно дополнительно проверить кровь.
При ярко протекающей болезни визуально в крови
обнаруживается гемолиз (разрушенные эритроциты придают сыворотке крови красный
цвет различных оттенков).
Проведение иммунологического теста для
обнаружения антител к пироплазмозу - реакция часто дает ложные результаты, к
тому же антитела могут быть от предыдущего заболевания, или при естественной
устойчивости организма при попадании паразитов образуется иммунитет, а болезнь
не развивается.
Исследование мазков крови под микроскопом и
обнаружение бабезий в эритроцитах. Это наиболее часто используемое исследование
для подтверждения пироплазмоза собак. К сожалению не всегда наличие паразитов
доказывает развитие пироплазмоза, (это может быть хроническая форма болезни или
носительство после предыдущего заболевания пироплазмозом или у
природноустойчивых животных) и наоборот даже при яркой форме болезни не во всех
мазках крови обнаруживаются пироплазмы. Причем капиллярная или венозная
используется кровь не очень важно, важнее в этой ситуации сделать несколько
мазков из вены и из уха (или когтя).
. Следующий этап диагностики исключение других
похожих заболеваний, к ним относятся:
Лептоспироз и гломерулонефрит
Различные поражения печени
Исследования крови по методу романовского - Гимзе
На чистое, обезжиренное предметное стекло
наносят первую каплю периферической крови (лучше из уха) и при помощи
шлифованного или покровного стекла делают тонкий средней длины мазок. Чтобы
ускорить высыхание, несколько раз взмахивают мазком. На мазке иглой отмечают
вид животного, время и место взятия, после чего мазок заворачивают в бумагу и
направляют в лабораторию для фиксации, окраски, и исследования.
Окрашивают мазки чаще по методу Романовского в
течение 15-60 минут. Для приготовления рабочего раствора краски
Романовского-Гимзе на 1 мл дистиллированной воды берут 1-2 капли краски
(раствор краски подливают под мазок). Окрашенный препарат тщательно промывают
струей дистиллированной или дождевой (снеговой) воды и высушивают. Качество
мазка зависит от правильности приготовления и свежести мазка, доброкачественности
фиксатора и краски. Хорошо приготовленный и окрашенный мазок должен быть
тонким, ровным и заканчиваться зазубринками; цвет мазка розовый.
Окрашенные мазки рассматривают под иммерсионной
системой микроскопа. Пироплазмиды отчетливо видны на розовом фоне эритроцитов в
виде округлых и грушевидных включений, протоплазма которых голубого, а ядро -
красно-фиолетового цвета.
7. Патологоанатомические изменения
Труп истощен. Видимые слизистые оболочки
бледно-желтого цвета. Из отверстий естественных нередко выделяется кровь.
Подкожная соединительная ткань желтушна. Кровь водянистая. Печень увеличена
сильно, уплотнена, бледно-глинистого цвета. Желчный пузырь растянут густой
красно-желтой желчью. Селезенка увеличена, темно-красного цвета; ее фолликулы
хорошо заметны. Почки гиперемированы; корковый и мозговой слои резко
отграничены. Мочевой пузырь наполнен мочой красного цвета; слизистая его
набухшая, гиперемирована, иногда с кровоизлияниями. В сердечной сорочке находится
желтоватая жидкость. Мышца сердца бледная, плотная. Легкие бледные, часто
усеянные с поверхности мелкими кровоизлияниями. Бронхиальные и мезентериальные
лимфатические узлы несколько увеличены и на разрезе сочны.
. Лечение
Лечение пироплазмоза собак состоит из 3
направлений:
. Лекарственные средства, непосредственно
убивающие паразитов, вводятся внутримышечно 1, иногда 2 раза. Очень важное
значение имеет раннее начало лечения - при этом внешнее выздоровление наступает
уже через 1 - 2 дня, в запущенных случаях лечение осложнений пироплазмоза
затягивается на 5 - 20 дней и не всегда приводит к выздоровлению. Через
несколько часов после инъекции Верибена начинается массовая гибель бабезий и
разрушение пораженных эритроцитов, в последующем все остатки клеток выделяются
через почки, закупоривая почечные канальцы - что в большей степени и
обуславливает осложнения пироплазмоза в виде почечной недостаточности собак.
. Поддерживающая терапия в зависимости от
тяжести общего состояния собаки. Включает в себя: капельницы, сердечные
средства, почечные отвары, препараты для восстановления эритроцитов и др.
. Лечение осложнений пироплазмоза собак.
Самым частым и тяжелым осложнением пироплазмоза
является почечная недостаточность собак, особенно тяжело бывает старым животным
и тем, у кого уже были заболевания почек. Почечная недостаточность собак может
протекать с нарушением выделительной функции почек, но с сохранением выработки
мочи - это более легкий вариант, и гораздо хуже когда уменьшается или полностью
перестает вырабатываться моча - лечение таких животных возможно только с
использованием различных методов гемодиализа (гемодиализ - очищение крови при
помощи фильтров вне организма). Наилучшие результаты для защиты почек дает
проведение гемосорбции (разновидность гемодиализа - очищения крови) через 6 -
24 часа после начала специфического лечения. При пироплазмозе собак гибнет
значительное количество эритроцитов, поэтому понижаются возможности организма
снабжать органы и ткани кислородом - развивается сердечно-легочная недостаточность.
В легких случаях используют препараты улучшающие и поддерживающие работу
сердца, в более сложных - используют оксигенацию (дают дышать кислородом),
крайне редко приходится прибегать к переливанию крови. При поражении печени,
что связано с токсичностью лечебных препаратов и в целом тяжелого протекания
болезни - применяют курсовое лечение капельницами с 5 % глюкозой и дополнением
гепатопротекторов, при прогрессировании нарушений в работе печени можно
дополнительно использовать плазмаферез и гемосорбцию. Сочетанное поражение
почек, печени и сердечнососудистой систем практически не оставляет надежд на
выздоровление, в основном это бывает в запущенных случаях болезни, поэтому
очень важное значение имеет раннее начало лечения - при этом внешнее выздоровление
наступает уже через 1 - 2 дня, в запущенных случаях лечение осложнений
пироплазмоза затягивается на 5 - 20 дней и не всегда приводит к выздоровлению.
В настоящее время высокоэффективными средствами
являются Имидосан и Фортикарб. В некоторых ветеринарных службах по старой
технологии используют азидин (беренил), который применяют в дозе 0,0035 г/кг
массы тела, внутримышечно, в виде 7%-ного водного раствора. Если температура
тела на 2-й день не снижается, то лекарство вводят повторно. Можно применять и
другие противопироплазмидозные средства: эффективно внутривенное введение
трипанблау (трипансинь) в форме 1%-ного раствора на 0,3-0,4%-ном растворе
хлористого натрия в дозе от 0,5 до 1,0 мл/кг массы тела; пироплазмин (акаприн)
вводят подкожно в виде 0,5%-ного водного раствора в дозах 0,5-2,0 мл одному
животному; диамидин назначают внутримышечно или подкожно в дозе 1-2 мг/кг в
10%-ном растворе дистиллированной воды.
Перед лечением специфическими препаратами
необходимо применить сердечные средства. Обязательно применяют также
слабительные, тонизирующие и крововосстанавливающие препараты.
После выздоровления собак необходимо ограничить
в движении в течение 10-15 суток. Не рекомендуется эксплуатировать переболевших
охотничьих собак в текущем сезоне.
Иммунитет. После выздоровления наблюдается
нестерильный иммунитет продолжительностью 1-2 года.
. Профилактика. Рекомендация владельцу
Профилактика заболевания пироплазмоза направлена
на предупреждение нападения клещей на собак. Для этого используют инсекто-акарицидные
средства различных видов и путей обработки: ошейники, капли на холку, спрэи,
шампуни. На российском рынке широко представлены следующие высокоэффективные
препараты RolfClub. В местах, где болезнь наблюдается постоянно, служебным
собакам в летний период каждые 10 дней вводят азидин, что предупреждает
заболевание. При поездках в неблагополучные по пироплазмозу зоны собакам с
профилактической целью вводят противопироплазмидозный препарат (азидин в дозе
2,5 мг/кг массы тела).
Вакцина против пироплазмоза называется Пиродог.
Вакцина содержит выделенный антиген пироплазмоза. В отличие от большинства
вакцин прививка Пиродог дает слабый иммунитет, но ее главная задача уменьшить
количество смертельных исходов в случае заболевания собаки пироплазмозом.
пироплазмоз болезнь собака токсин
Литература
2. «Методы ветеринарной
клинической лабораторной диагностики», Под ред. проф. И.П. Кондрахина: М. «КолосС»,
2004.